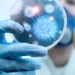
Un virus, cu mortalitate de zeci de ori mai mare decât COVID-19, ar putea devasta omenirea

Aproape 50 de milioane de alegători francezi sunt chemaţi la urne, pentru a stabili noua componenţă a Adunării Naţionale, adică numirea a 577 de deputaţi, în două tururi, duminică şi 7 iulie, ceea ce ar putea schimba radical peisajul politic politic în Hexagon, scrie Digi24.ro.
Secțiile s-au deschis în teritoriile de peste mări
Birourile de vot s-au deschis sâmbătă, în unele teritorii de peste mări, pentru primul tur al celor mai urmărite alegeri legislative din Franţa, în care extrema dreaptă este marea favorită, în faţa stângii şi mult înaintea taberei prezidenţiale.
Primii care au mers la urne au fost alegătorii francezi din Saint Pierre şi Miquelon, arhipelag în Atlanticul de Nord, aproape de Canada, unde birourile de vot s-au deschis sâmbătă la ora locală 08:00 (10:00 GMT), ei fiind urmaţi de cei din Antile, Guyana, Polinezia Franceză şi cei care trăiesc pe continentul american.
Câteva militante ale mişcării feministe Femen au desfăşurat, sâmbătă, o acţiune la Trocadero, vizavi de Turnul Eiffel: cu sânii goi şi acoperiţi cu sloganuri împotriva extremei drepte, curăţând locul cu „dizolvant antirasism”.
„Două dinamici”
Instituţiile de sondare a opiniei publice şi politicienii se aşteaptă la o creştere accentuată a prezenţei la vot în comparaţie cu alegerile legislative din 2022, când s-a înregistrat o participare la vot de 47,51%. De data aceasta s-ar putea ajunge la două treimi din alegătorii înregistraţi.
Aceasta se datorează în parte consecinţelor potenţial istorice ale actualelor alegeri legislative.
Există „două dinamici”, analizează Brice Teinturier, de la Institutul de sondare a opiniei publice Ipsos. „Una este o dinamică a speranţei, alegătorii de stânga spun că, dintr-o dată, poate exista o alternanţă (…) şi aceasta se referă şi mai mult la alegătorii RN”.
„Şi alt motor de mobilizare este politizarea negativă, frica, teama suscitată de RN şi, pentru o parte a electoratului de asemenea de coaliţia de stânga”, Noul Front Popular (NFP), care reuneşte Partidul Socialist, ecologiştii, Partidul Comunist şi Franţa Nesupusă (La France insoumise, stânga radicală).
Ce spun sondajele
Două sondaje de opinie publicate vineri creditează tabăra extremei drepte cu 35%, respectiv 36,5% din intenţiile de vot, NPF – cu 27,5-29%, iar tabăra macronistă – cu 20,5-21%.
Potrivit unor sondaje, obţinerea majorităţii absolute este acum posibilă pentru RN şi aliaţii săi. Presiunea este mai puternică în tabăra prezidenţială. Acesta din urmă a promis joi „cea mai mare claritate” cu privire la atitudinea de urmat între cele două tururi de scrutin.
Campania de trei săptămâni, marcată de incidente pe teren, s-a încheiat cu acuzaţiile lui Gabriel Attal de rasism la adresa candidaţilor RN.
Dacă Jordan Bardella ar deveni prim-ministru, ar fi pentru prima dată de la al Doilea Război Mondial când un guvern de extremă dreapta ar conduce Franţa.
Macron a dizolvat Adunarea Națională
Preşedintele Emmanuel Macron a provocat aceste alegeri anticipate, anunţând dizolvarea Adunării pe 9 iunie, în seara victoriei extremei drepte la alegerile europene.
Sondajele de opinie şi politicienii se aşteaptă la o participare mult mai mare decât la alegerile legislative din 2022, când s-au prezentat la urne 47,51% dintre alegători. De data aceasta, prezenţa la vot ar putea ajunge la două treimi din alegătorii înregistraţi.
Semne ale prezenţei ridicate aşteptate: votul online, deschis până joi cetăţenilor francezi care locuiesc în străinătate, a atins un număr record de 410.000 (250.000 în 2022).